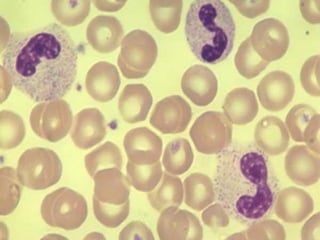

Este documento describe los principales componentes de la sangre y sus funciones. La sangre está compuesta de plasma y elementos figurados como eritrocitos, leucocitos y trombocitos. Los eritrocitos transportan oxígeno y dióxido de carbono, los leucocitos participan en la respuesta inmune, y los trombocitos ayudan a la coagulación sanguínea. El documento también describe las diferentes clases de leucocitos como neutrófilos, linfocitos, monocitos, eosinófilos y basófilos, y sus func